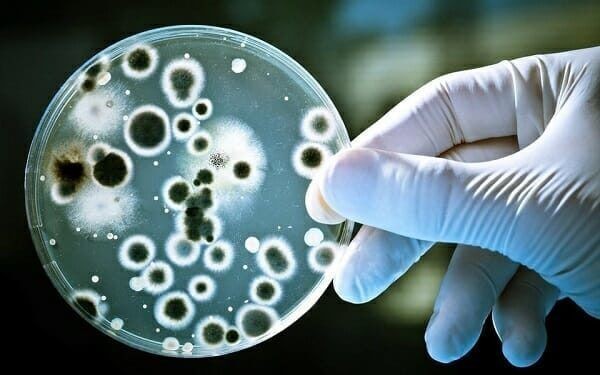
Phenoxyetanol là gì?

Nội dung bài viết
Với những người yêu thích mỹ phẩm thì cái tên Phenoxyethyl chắc chắn không còn xa lạ nữa, bởi chúng là thành phần phổ biến trong mỹ phẩm. Tuy nhiên, hiện nay có nhiều ý kiến cho rằng đây là chất độc hại và không nên sử dụng. Vậy Phenoxyetanol có thực sự độc hại? ENGCHEM sẽ cùng bạn đi tìm câu trả lời qua bài viết sau đây!
1. Phenoxyetanol là gì? Các tính chất và đặc điểm là gì?
1.1 Định nghĩa Phenoxyetanol
Phenoxyetanol là chất lỏng không màu, có mùi dễ chịu. Khi đun nóng, nó phân hủy và phát ra khói sáng có mùi khó chịu. Nó là sản phẩm của phản ứng giữa phenol và ethylene oxit ở nhiệt độ cao.
Đây là một trong những chất bảo quản gốc dầu, được sử dụng trong hầu hết các loại mỹ phẩm chăm sóc da, giúp bảo vệ chất lượng sản phẩm lâu dài khỏi các yếu tố như nấm mốc, hư hỏng. …
Phenoxyetanol là một glycol ete dùng làm chất cố định giúp diệt khuẩn, xua đuổi côn trùng, khử trùng,… Không những vậy, Phenoxyetanol còn là một phenol ete và rượu thơm thường được sử dụng cùng với các hợp chất amoni bậc một. bốn.
Hóa chất này được phát hiện có đặc tính kháng khuẩn, hoạt động như một tác nhân hiệu quả trong dược phẩm, mỹ phẩm và chất bôi trơn.
Phenoxyetanol thường được sản xuất bằng cách hydroxyethyl hóa phenol.
Phenoxyetanol là gì?
1.2. Tính chất của Phenoxyetanol
- Pure Chemical Phenoxyetanol là một loại dầu lỏng trong suốt, không màu
- Có mùi nhẹ ở nhiệt độ phòng, ít tan trong nước và dễ bay hơi
- Phenoxyetanol có khả năng chịu được nhiệt độ cao, ổn định ở 85 độ C và hoạt động ở pH 3 – 10,
- Nó ít tan trong nước nhưng tan trong hầu hết các loại dầu và ít bay hơi
2. Công dụng của Phenoxyetanol trong thực tế

Phenoxyetanol là chất bảo quản trong dược phẩm và mỹ phẩm
2.1. Là chất bảo quản, nó tạo ra hệ thống đệm sinh học
Phenolxyanol là chất có khả năng ngăn ngừa nấm men, vi khuẩn, nấm mốc trong sản phẩm giúp đảm bảo chất lượng và an toàn cho người sử dụng.
Các công thức sản phẩm chăm sóc da và vệ sinh cá nhân cho cả người lớn và trẻ em thường chứa Phenoxyethyl. Bởi nếu không có chất bảo quản này, vi khuẩn sẽ phát triển nhanh chóng trong sản phẩm và gây hại cho người dùng.
2.2. Là chất xúc tác giúp vi khuẩn có lợi hoạt động và ổn định kem
Phenoxyetanol còn là chất xúc tác giúp các chất có lợi phát huy tác dụng. Tuy không có tác động lớn đến da nhưng chúng lại là chất xúc tác có lợi giúp các protein, allantion, glycerin,… trong mỹ phẩm phát huy tác dụng trên da hiệu quả hơn.
3. Ứng dụng của Phenoxyetanol là gì?
Với tỷ lệ sử dụng thì chất bảo quản Phenoxyetanol đã được chứng nhận an toàn khi sử dụng trong các sản phẩm mỹ phẩm chỉ sử dụng dưới 1%. Vì vậy, nó thường được sử dụng trong nhiều loại mỹ phẩm và sản phẩm chăm sóc cá nhân như:
- Kem dưỡng da, dưỡng ẩm
- Dầu gội, dưỡng tóc
- Sơn móng tay, nước rửa tay
- Kem đánh răng, kem chống nắng
- Khử mùi
- Ổn định mùi hương trong nước hoa và nước hoa…
4. Phenoxyetanol có độc không?

Phenoxyetanol có an toàn không?
Nó có chứa trong thành phần của các sản phẩm chăm sóc và vệ sinh da dành cho trẻ em. Nếu không có hóa chất này, vi khuẩn sẽ phát triển ngược và gây hại cho người sử dụng. Các hãng mỹ phẩm nổi tiếng như Paulachoice's, Vichy, Hada lab, Skill… đều có chứa Phenoxyethyl. Vậy nếu là chất độc hại, liệu các thương hiệu lớn có dám sử dụng?
Chắc chắn đây không phải là hóa chất độc hại nhưng do được sử dụng đúng tiêu chuẩn về nồng độ nên vừa có thể phát huy tác dụng của Phenoxyetanol, vừa đảm bảo an toàn cho người sử dụng. Phenoxyetanol thường nằm ở cuối bảng thành phần nên tỷ lệ nồng độ sử dụng thấp và phù hợp với sự cho phép của cơ quan an toàn hóa chất.
5. Nên sử dụng phenoxyetanol ở nồng độ an toàn nào?
Ở nồng độ thấp (dưới 1%), Phenoxyetanol hoàn toàn vô hại và chỉ có tác dụng như chất bảo quản. Các sản phẩm chăm sóc da được phép sử dụng nồng độ chất bảo quản từ 0,4 đến dưới 1% ở các nước như Mỹ, Nhật Bản,…
Phenoxyanol nếu có nồng độ quá cao trong sản phẩm có thể gây ra các hiện tượng như ức chế thần kinh, tiêu chảy, nôn mửa. Nếu nồng độ hơi cao hơn 2,2% có thể gây kích ứng, ngứa mắt và nghiêm trọng hơn là gây ung thư vú ở phụ nữ.
Kết luận: Phenoxyetanol ở nồng độ dưới 1% không phải là chất độc hại trong bảo quản mỹ phẩm. Và mọi người nên yên tâm khi sử dụng hóa chất này.
Xem thêm: DUNG DỊCH METHANOL CÔNG NGHIỆP VÀ ỨNG DỤNG THƯỜNG GẶP TRONG CUỘC SỐNG

Nội dung được phát triển bởi đội ngũ truongchuvananhue.edu.vn với mục đích chia sẻ và tăng trải nghiệm khách hàng. Mọi ý kiến đóng góp xin vui lòng liên hệ tổng đài chăm sóc: 1900 0000 hoặc email: hotro@truongchuvananhue.edu.vn